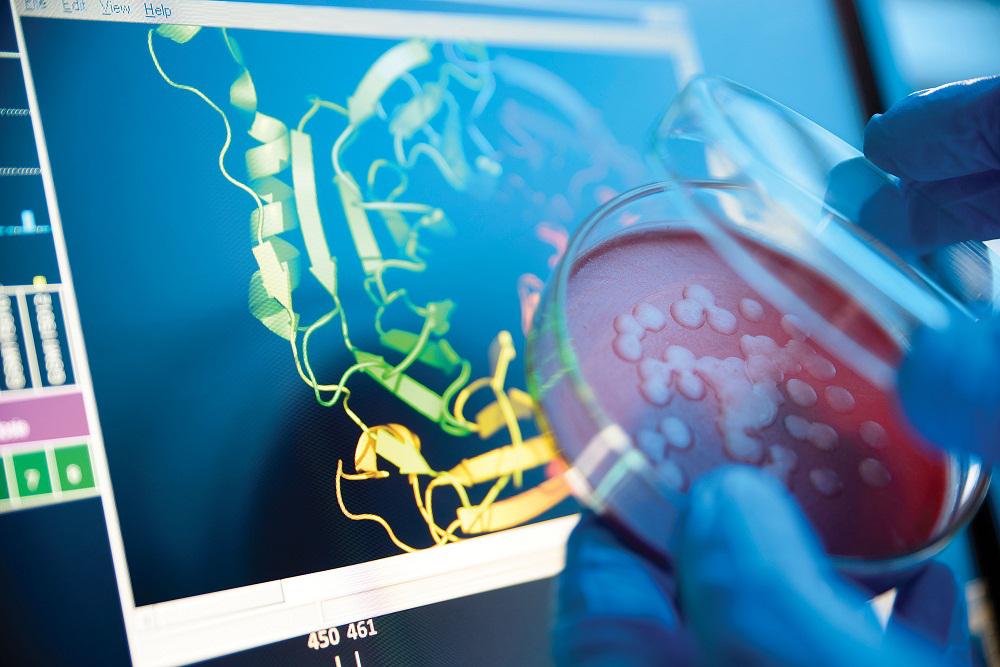

Press release
Protein Characterization Instrument: Market 2018 Global Analysis By Top Key Players – Agilent Technologies, Bio-Rad Laboratories, Bruker, Danaher, GE, Perkin Elmer, Shimadzu, Sigma-Aldrich
An exclusive Protein Characterization Instrument market research report created through broad primary research (inputs from industry experts, companies, and stakeholders) and secondary research, the report aims to present the analysis of Global Protein Characterization Instrument Market By Type, By Application, By Region - North America, Europe, South America, Asia-Pacific, Middle East and Africa. The report intends to provide cutting-edge market intelligence and help decision makers take sound investment evaluation. Besides, the report also identifies and analyses the emerging trends along with major drivers, challenges and opportunities in the global Protein Characterization Instrument market. Additionally, the report also highlights market entry strategies for various companies across the globe.Protein Characterization Instrument Market Players:
· Agilent Technologies (U.S.)
· Bio-Rad Laboratories, Inc. (U.S.)
· Bruker Corp. (U.S.)
· Danaher Corp. (U.S.)
· GE Healthcare (U.K.)
· Perkin Elmer (U.S.)
· Shimadzu Corp. (Japan)
· Sigma-Aldrich Corp. (U.S.)
· Thermo Fisher Scientific (U.S.)
· Waters Corp. (U.S)
Get Sample Copy of This Report Now @ https://www.qyresearchgroups.com/request-sample/1071336
Market size by Product
· Chromatography Instruments
· Electrophoresis Instruments
· Label-free Detection Instruments
· Mass Spectrometery
· Spectroscopy Instruments
· Others
Market size by End User
· Clinical Diagnosis
· Drug Discovery and Development
· Others
Major regions are as follows:
· United States
· Europe
· China
· Japan
· Southeast Asia
· India
· Central & South America
· Other Regions
Get Exclusive Discount @ https://www.qyresearchgroups.com/check-discount/1071336
Worldwide Protein Characterization Instrument Market Analysis to 2025 is a specialized and in-depth study of the Protein Characterization Instrument industry with a focus on the global market trend. The report aims to provide an overview of global Protein Characterization Instrument market with detailed market segmentation by product/application and geography. The global Protein Characterization Instrument market is expected to witness high growth during the forecast period. The report provides key statistics on the market status of the Protein Characterization Instrument players and offers key trends and opportunities in the market.
Also, key Protein Characterization Instrument market players influencing the market are profiled in the study along with their SWOT analysis and market strategies. The report also focuses on leading industry players with information such as company profiles, products and services offered, financial information of last 3 years, key development in past five years.
Reason to Buy
- Highlights key business priorities in order to assist companies to realign their business strategies.
- The key findings and recommendations highlight crucial progressive industry trends in the Protein Characterization Instrument market, thereby allowing players to develop effective long term strategies.
- Develop/modify business expansion plans by using substantial growth offering developed and emerging markets.
- Scrutinize in-depth global market trends and outlook coupled with the factors driving the market, as well as those hindering it.
- Enhance the decision-making process by understanding the strategies that underpin commercial interest with respect to products, segmentation and industry verticals.
BUY NOW Full Report @ https://www.qyresearchgroups.com/checkout/1071336
Contact Us:
Call: +1-888-236-2744
Email: sales@qyresearchgroups.com
About Us:
QY Research Groups is a company that simplifies how analysts and decision makers get industry data for their business. Our unique colossal technology has been developed to offer refined search capabilities designed to exploit the long tail of free market research whilst eliminating irrelevant results. QY Research Groups is the collection of market intelligence products and services on the Web. We offer reports and update our collection daily to provide you with instant online access to the world's most complete and current database of expert insights on global industries, companies, products, and trends.
Room B1510, Shiji Kemao Building,
No.66 Zhongguancun East Road,
Haidian District, Beijing,
100190, China.
This release was published on openPR.
Permanent link to this press release:
Copy
Please set a link in the press area of your homepage to this press release on openPR. openPR disclaims liability for any content contained in this release.
You can edit or delete your press release Protein Characterization Instrument: Market 2018 Global Analysis By Top Key Players – Agilent Technologies, Bio-Rad Laboratories, Bruker, Danaher, GE, Perkin Elmer, Shimadzu, Sigma-Aldrich here
News-ID: 1245502 • Views: …
More Releases from QY Research Groups
Sanitary Pads Market Growth Statistics and Key Players Insights: P&G, Kimberly C …
A sanitary pad is an absorbent item worn by women who are menstruating, bleeding after giving birth, recovering from gynecologic surgery, experiencing a miscarriage or abortion, or in any other situation where it is necessary to absorb a flow of blood from the vagina.
The Sanitary Pads report is an exclusive elaborated study of the given industry with an aim towards the global market trend. The report focuses to deliver a…
Thermoplastic Hose Market 2019 Analysis The Global Key Players: Kurt Hydraulics, …
The global analysis report titled as Thermoplastic Hose Market has recently published by QY Research Groups to its huge repository which helps to make informed decisions in the businesses. It includes a comprehensive analysis of the market. This research report throws light on historical records, existing market scenario and future predictions of market growth. Primary and secondary research methodologies have been used for examining the global Thermoplastic Hose Market. It…
Pallet Pooling Market 2019 SWOT Analysis By Players; Brambles Limited, Buckhorn, …
The global analysis report titled as Pallet Pooling Market has recently published by QY Research Groups to its huge repository which helps to make informed decisions in the businesses. It includes a comprehensive analysis of the market. This research report throws light on historical records, existing market scenario and future predictions of market growth. Primary and secondary research methodologies have been used for examining the global Pallet Pooling Market. It…
Manufactured Housing Market 2019 SWOT Analysis By Major Eminent Players; Clayton …
The global analysis report titled as Manufactured Housing Market has recently published by QY Research Groups to its huge repository which helps to make informed decisions in the businesses. It includes a comprehensive analysis of the market. This research report throws light on historical records, existing market scenario and future predictions of market growth. Primary and secondary research methodologies have been used for examining the global Manufactured Housing Market. It…
More Releases for Instrument
Market Unveiling Promising Growth with Major Giants| National Instrument, GS Ins …
The latest released on Global Digital Network Analyzers Market delivers a comprehensive data ecosystem with a 360° view of customer activities, segment-based analytics-and-data to drive opportunities of evolving Digital Network Analyzers marketplace and future outlook to 2029. It includes integrated insights into surveys conducted with executives and experts from leading institutions across various countries. Some of the listed companies profiled in the report are Keysight Technologies, Rohde & Schwarz, Anritsu,…
Cutting-Edge Clarify Tester for Analysis | NANBEI, BIOBASE GROUP, FAITHFUL Instr …
Clarify Tester Market 2023 Forecast: Unveiling Opportunities and Growth
Clarify Tester market report presents an overview of the market on the basis of key parameters such as market size, revenue, sales analysis and key drivers. The market size of global Clarify Tester market is anticipated to grow at large scale over the forecast period (2023-2029). The main purpose of the study report is to give users an extensive viewpoint of the…
Global Automotive Instrument Cluster Market
All of the top selling models in Europe feature hybrid instrument cluster.
The 2 wheelers are sold in high numbers in Asia region, account for a sizeable instrument cluster market volume in the region.
The digital instrument cluster market accounts for a small share of the market but has been growing at the fastest rate,especially in China.
VW now offers biggest range of Digital instrument cluster starting from Polo, Golf, to…
Hv Instrument Transformers Market 2025: Top Key Players Hengyang Nanfang Instrum …
HV Instrument Transformers Market: Introduction
HV instrument transformers or high voltage instrument transformers are designed to measure and convert high current and high voltage to low current and low voltage according to the transformer ratio. HV instrument transformers are used in AC systems for the measurement of electrical quantities, such as current, voltage, power, energy, power factor and frequency. HV instrument transformers are essential constituents for the safe and efficient operation…
Hv Instrument Transformers Market Participants Siyuan Electric Co. Ltd Hengyang …
HV Instrument Transformers Market: Introduction
HV instrument transformers or high voltage instrument transformers are designed to measure and convert high current and high voltage to low current and low voltage according to the transformer ratio. HV instrument transformers are used in AC systems for the measurement of electrical quantities, such as current, voltage, power, energy, power factor and frequency. HV instrument transformers are essential constituents for the safe and efficient operation…
Global Beauty Instrument Market 2018 Stryker, Medtronic, Johnson & Johnson, Beau …
Beauty Instrument Market Summary
Global Beauty Instrument Market Size, Share, Growth, Trends, Regional Outlook, and Forecasts, 2018 - 2025' to its vast database of research reports. This intelligence study focuses on the current market trends and development patterns, in order to assist the new entrants in discovering market opportunities and develop effective ways to expand their presence in the global market.
Get a Sample PDF Report : https://is.gd/tjJnMl
This research report provides…